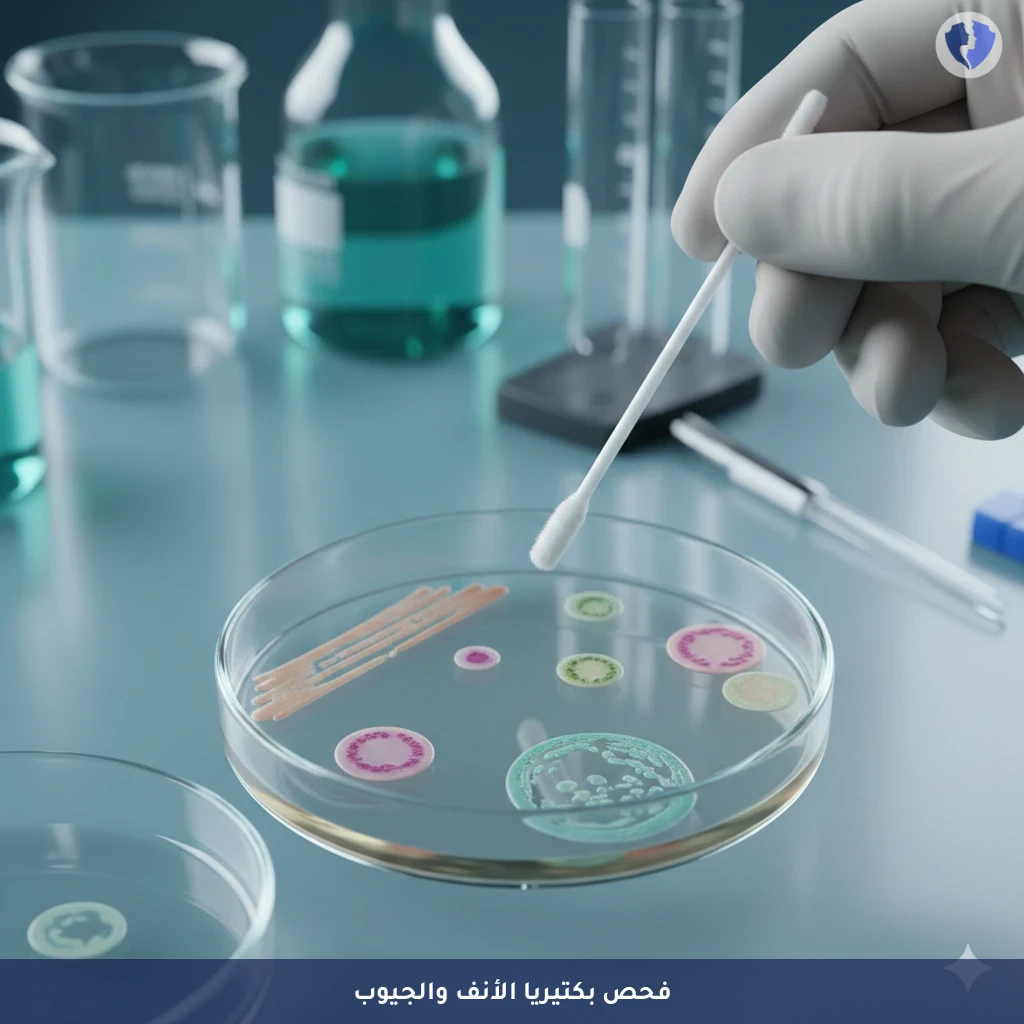
مزرعة مسحة الأنف والجيوب - مسحة ومزرعة من الأنف (Nose Swab Culture)

تفاصيل الخدمة
مزرعة مسحة الأنف والجيوب - مسحة ومزرعة من الأنف (Nose Swab Culture)
فحص ميكروبيولوجي تشخيصي يتم فيه جمع عينة من بطانة الأنف (عادة من الجزء الأمامي من المنخرين أو البلعوم الأنفي) باستخدام مسحة معقمة. تُزرع العينة على أوساط انتقائية وغنية للعزل الأولي للبكتيريا والفطريات. بعد الحضانة، يتم تحديد هوية البكتيريا المسببة للأمراض (مثل المكورات العنقودية الذهبية، المكورات الرئوية) وإجراء اختيار الحساسية للمضادات الحيوية (Antibiogram) عليها لتوجيه العلاج الدوائي الأمثل.